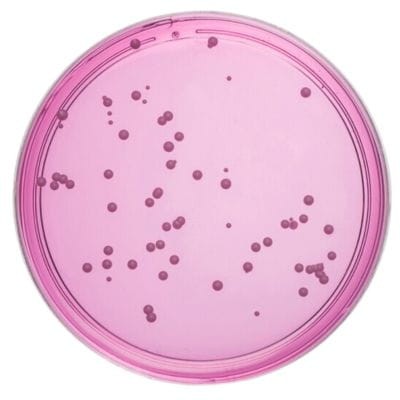
Dichloran_Rose_Bengal_Chloramphenicol_Medium_gotowa_pożywka_na_płytkach_Bestlabs.jpg

Dichloran Rose-Bengal Chloramphenicol Medium gotowa pożywka na płytkach
• Opakowanie: 10 szt.
• Płytka: 90 mm.
• Do oznaczania drożdży i pleśni
 Opis
Opis
Dichloran Rose-Bengal Chloramphenicol Medium – gotowa pożywka na płytkach do oznaczania drożdży i pleśni
Gotowe podłoże mikrobiologiczne Dichloran Rose-Bengal Chloramphenicol Medium to niezawodne rozwiązanie do precyzyjnego wykrywania i oznaczania drożdży oraz pleśni. Produkt zaprojektowany z myślą o laboratoriach mikrobiologicznych, zapewnia efektywność i wygodę użytkowania w analizach mikrobiologicznych próbek żywności i innych materiałów biologicznych.
Charakterystyka Dichloran Rose-Bengal Chloramphenicol Medium
Selektywne właściwości
Podłoże zawiera kluczowe składniki, takie jak dichloran, róż bengalski oraz chloramfenikol, które skutecznie hamują wzrost bakterii, jednocześnie umożliwiając rozwój drożdży i pleśni. Dzięki selektywnej formule pożywka zapewnia dokładność wyników i minimalizuje ryzyko interferencji ze strony innych mikroorganizmów.
Wizualna ocena kolonii
Dodatek różu bengalskiego pozwala na łatwą identyfikację kolonii drożdży i pleśni dzięki ich intensywnemu zabarwieniu, co przyspiesza proces analizy i interpretacji wyników.
Specyfikacja produktu
Opakowanie i wymiary
- Ilość sztuk w opakowaniu: 10 sztuk.
- Średnica płytki: 90 mm.
Przeznaczenie
- Wykrywanie drożdży i pleśni w próbkach żywności, pasz oraz innych materiałach biologicznych.
Gotowa forma produktu
Płytki są w pełni przygotowane do użytku, co eliminuje konieczność samodzielnego przygotowywania podłoży, oszczędzając czas i zasoby laboratoryjne.
Zastosowanie Dichloran Rose-Bengal Chloramphenicol Medium
Wykrywanie drożdży i pleśni w żywności
Podłoże jest powszechnie stosowane w laboratoriach mikrobiologicznych zajmujących się kontrolą jakości żywności i pasz. Zapewnia szybkie i wiarygodne wyniki w próbkach takich jak:
- Produkty mleczne.
- Warzywa i owoce.
- Produkty piekarnicze.
- Surowce spożywcze.
Badania środowiskowe
Dzięki selektywnym właściwościom podłoże może być również stosowane w badaniach środowiskowych, w tym w próbkach powietrza, gleby oraz wody, w celu wykrycia obecności pleśni i drożdży.
Zalety Dichloran Rose-Bengal Chloramphenicol Medium
Precyzyjna selekcja mikroorganizmów
Dzięki zawartości chloramfenikolu, pożywka skutecznie ogranicza rozwój bakterii, co pozwala na izolację i identyfikację wyłącznie drożdży i pleśni.
Łatwa interpretacja wyników
Dodatek różu bengalskiego ułatwia rozpoznanie kolonii, pozwalając na szybką ocenę próbek.
Optymalna forma użytkowa
Produkt dostarczany w gotowej formie płytkowej eliminuje potrzebę przygotowywania podłoża, co znacząco redukuje czasochłonność procesów laboratoryjnych.
Niezawodność w badaniach mikrobiologicznych
Produkt spełnia wysokie standardy jakości, zapewniając dokładne wyniki niezbędne do oceny bezpieczeństwa żywności i materiałów biologicznych.
Instrukcja stosowania
- Wyjmij płytkę z opakowania w warunkach sterylnych.
- Nanieś badaną próbkę na powierzchnię podłoża.
- Inkubuj płytkę w zalecanej temperaturze zgodnie z wytycznymi metody analitycznej.
- Po inkubacji zidentyfikuj kolonie drożdży i pleśni na podstawie ich charakterystycznego wyglądu.
Podsumowanie
Dichloran Rose-Bengal Chloramphenicol Medium to niezastąpione narzędzie w analizach mikrobiologicznych, dedykowane do wykrywania drożdży i pleśni w próbkach żywności i środowiskowych. Dzięki selektywnym składnikom i gotowej formie płytki produkt umożliwia precyzyjne, szybkie i wygodne przeprowadzenie analiz, spełniając potrzeby nowoczesnych laboratoriów.
W powyższym linku znajdą Państwo bazę aktualnych certyfikatów firmy OXOID. Wystarczy wpisać numer LOT zamówionej przez Państwa partii, w celu uzyskania odpowiedniego certyfikatu.
 Koszty dostawy
Cena netto, nie zawiera podatku
Koszty dostawy
Cena netto, nie zawiera podatku
darmowa i wygodna wysyłka
już od 800 zł netto
Najwyższa jakość
produktów potwierdzona certyfikatami
Zakupy 24h na dobę
wygodne i bezpieczne
bezpłatna konsultacja
z ekspertem online